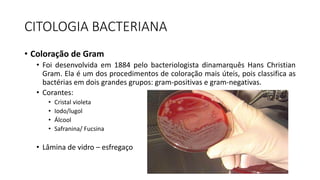
CITOLOGIA BACTERIANA
• Coloração de Gram
• Foi desenvolvida em 1884 pelo bacteriologista dinamarquês Hans Christian
Gram. Ela é um dos procedimentos de coloração mais úteis, pois classifica as
bactérias em dois grandes grupos: gram-positivas e gram-negativas.
• Corantes:
• Cristal violeta
• Iodo/lugol
• Álcool
• Safranina/ Fucsina
• Lâmina de vidro – esfregaço

O documento descreve a citologia bacteriana, incluindo os principais elementos estruturais das bactérias como a membrana plasmática, citoplasma, parede celular, cromossomo, plasmídeos e ribossomos. Também discute as diferenças entre as paredes celulares das bactérias Gram-positivas e Gram-negativas.